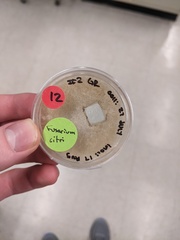
Fusarium citri
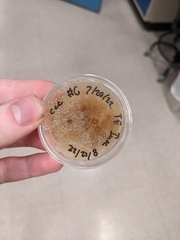
Fusarium citri

Fusarium citri: taxon details and analytics
- Domain
- Kingdom
- Fungi
- Phylum
- Ascomycota
- Class
- Sordariomycetes
- Order
- Hypocreales
- Family
- Nectriaceae
- Genus
- Fusarium
- Species
- Fusarium citri
- Scientific Name
- Fusarium citri
Summary description from Wikipedia:
Images from inaturalist.org observations:
We recommend you sign up for this excellent, free service.
Parent Taxon
Sibling Taxa
- Fusarium acuminatum
- Fusarium aethiopicum
- Fusarium anguioides
- Fusarium annulatum
- Fusarium arthrosporioides
- Fusarium asiaticum
- Fusarium avenaceum
- Fusarium aywerte
- Fusarium bambusarum
- Fusarium brachygibbosum
- Fusarium brevicaudatum
- Fusarium bulbicola
- Fusarium caeruleum
- Fusarium camptoceras
- Fusarium carpineum
- Fusarium cerealis
- Fusarium chlamydosporum
- Fusarium circinatum
- Fusarium citri
- Fusarium citri-sinensis
- Fusarium coffeatum
- Fusarium commune
- Fusarium compactum
- Fusarium concentricum
- Fusarium concolor
- Fusarium cortaderiae
- Fusarium cugenangense
- Fusarium culmorum
- Fusarium equiseti
- Fusarium falsibabinda
- Fusarium flocciferum
- Fusarium fujikuroi
- Fusarium georginae
- Fusarium graminearum
- Fusarium graminum
- Fusarium heterosporum
- Fusarium incarnatum
- Fusarium lacertarum
- Fusarium lateritium
- Fusarium limonis
- Fusarium longipes
- Fusarium longisporum
- Fusarium minimum
- Fusarium musarum
- Fusarium nelsonii
- Fusarium newnesense
- Fusarium nirenbergiae
- Fusarium nurragi
- Fusarium nygamai
- Fusarium osiliense
- Fusarium oxysporum
- Fusarium pallens
- Fusarium paspali
- Fusarium peltigerae
- Fusarium poae
- Fusarium proliferatum
- Fusarium putrefaciens
- Fusarium ramigenum
- Fusarium redolens
- Fusarium sacchari
- Fusarium sambucinum
- Fusarium sporotrichioides
- Fusarium sterilihyphosum
- Fusarium stilboides
- Fusarium subglutinans
- Fusarium trichothecioides
- Fusarium tricinctum
- Fusarium tumidum
- Fusarium urticearum
- Fusarium venenatum
- Fusarium xylarioides
- Fusarium xyrophilum
- Gibberella flacca
- Gibberella macrolopha